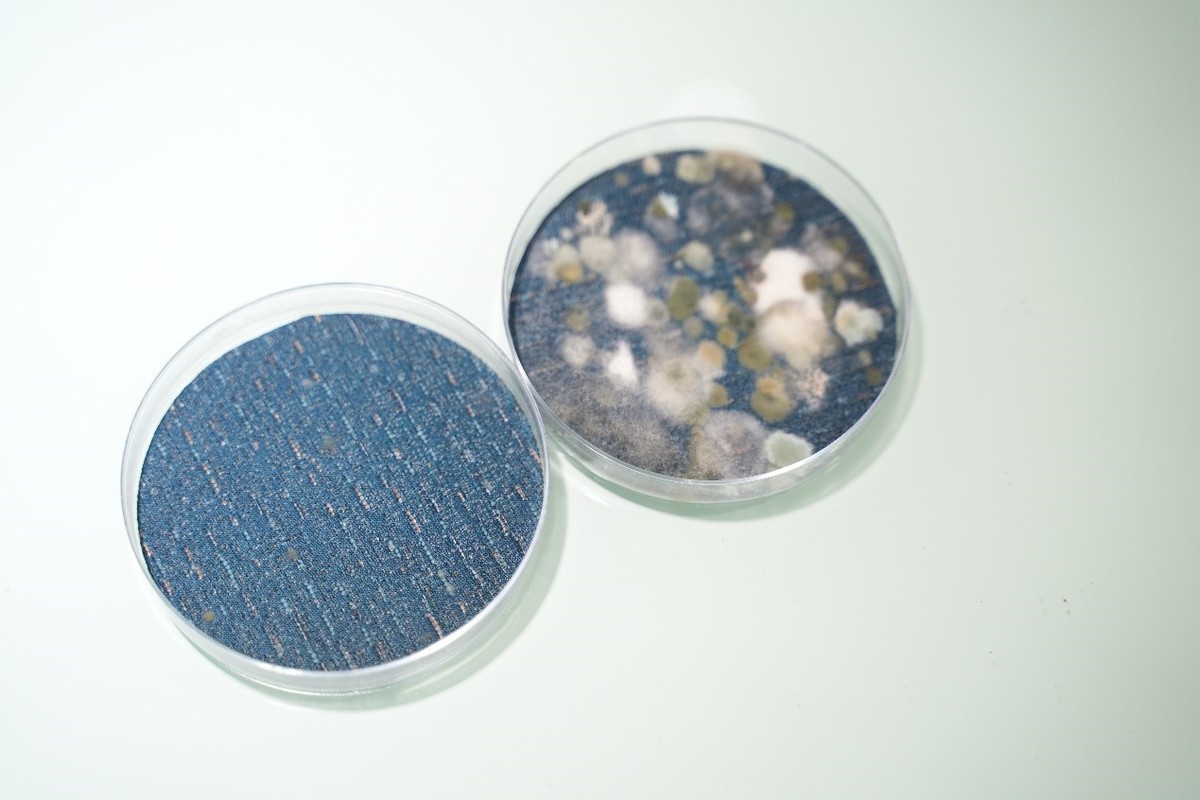
选窗帘防甲醛,选窗帘防尘螨

揭秘小白看不懂的窗帘面料细节,教你挑选耐用又好看的窗帘,避坑经验让你买窗帘少花冤枉钱!
今年刚开春儿的时候,媳妇嘱咐懂哥想办法把窗帘洗一下。搬过来3年多,家里窗帘就用刷子擦洗过一次。
懂哥卸窗帘前,准备看看表面脏不脏。结果翻到窗帘布后面,好家伙, 竟然发霉了!

▲我家的旧窗帘(已退役),懂哥拍于2022年4月
想起来当时挑窗帘着急搬家,在熟人店里随便定了一款。谁能料想到窗帘这么容易滋生霉菌!北方气候干燥窗帘都长霉,不知道南方的小伙伴怎么过啊。
然后还有个最现实的问题——去年我们有了宝宝,婴儿床摆在卧室窗边,宝宝到处摸碰很容易病从口入。 想到宝宝和发霉窗帘共处一室,哪能受得了! 我马上提议:“不如换个窗帘得了!”
因为疫情拖了又拖,和媳妇在网上研究了很久。最后确定换的某猫知名品牌的银离子抗菌窗帘。6月末,终于把家里窗帘都换啦!

选择窗帘店,我家踩过的5个坑
经过上次惨痛的经历,终于明白窗帘不只是“遮光的布料”,而是和家居健康息息相关,并且每副窗帘都定义着房间的风格,所以购买时不能大意。
懂哥总结了下面我认为普通人容易被店家坑的几个点,也是我们踩过的几个坑:
1、选店避雷:慎选小作坊的窗帘面料
无名小店的杂牌窗帘,表面看似高档,但布料甲醛超标是常事。窗帘布的加工、缝线、收边需要专业的制作流程,我们一开始找的小窗帘店里就有种说不出的味道,旧窗帘的做工瑕疵很多,比如线头、不明的小疙瘩、缝线错位,还有边缘处少料(很多地方是买回来挂上才发现),用久了变形、发霉很容易吃哑巴亏。

给层高2米7以上的窗户定制全窗帘子,在不规范的店里容易被加价。 如果选择定制,一般窗帘店给你按照窗户宽度 1.8~2倍 买窗帘布,而黑心窗帘店让按照窗帘 2.5倍 买窗帘布,买回挂起来一堆褶,商家不负责任的推销又血亏好几千。
2、窗帘附件猫腻很多
正规的窗帘厂家是在窗帘工艺上下功夫,使用的挂钩、挂杆等配件都是可选搭配。但碰到无良商家呢,你会被忽悠着加配各种窗帘扣、帘穗、帘头……小心下套!
如果你家装修比较奢华还好,很多人装的现代极简风格的家,装个古典主义巴洛克宫廷风窗帘,这看着别扭不别扭呀?

▲正规窗帘店不会有隐形加价和配饰强制消费,定制完全按实际需求来
3、服务和售后无保障不要选
我们之前的旧窗帘,还想着去那个店里问问,但过了这么久,人家店都关啦,之前的微信也联络不到了,售后保障、除螨服务这些就想都不要想。
4、好的网店比家装市场的游击店更靠谱
我们这次因为疫情,专心在网店找。天猫店定制窗帘的话,有可能比在实体店铺便宜很多还很贴心哦!
我们的经验是,首先要问能不能免费试挂成品帘实际看效果;其次,看来安装的师傅专业度如何;最后安装好的窗帘有多久的免费退换和售后保证。这种每家店服务差异很大,也是买窗帘后更舒心的一个关键点。
窗帘真的是大件,全屋窗帘买下来不是小数目,所以选择靠谱的品牌店也很重要。

5、窗帘款式选择自己心中要有数
很多热情的店员都会给你推荐流行的款式,但是否和自家风格搭配呢?除了可以要求商家提供成品帘的试挂服务之外,最好掌握点搭配窗帘的小技巧。
一般来说素色面料比花纹或刺绣面料要便宜,简单大方的涤纶混纺窗帘布也比奢华的绒布和高精密窗帘面料省不少钱。
普通家庭可以要 按照自己家中的主色调选窗帘颜色 ,我家就是根据各个房间床品和墙面颜色搭配窗帘的!如果想省事,纯灰色系窗帘可以闭眼入。
我再推荐适合国人家居的两种百搭颜色,一个暖色调、一个冷色调:

▲这是最初在 某猫 看上的一款,后来没选它。治愈系的晚霞色,特别温暖,房间有木色或浅色家具,非常搭调!

▲慵懒的青蓝调,可以缓解房间闷、燥的感觉,轻美式、中式、诧寂风的房间都适合。夏天视觉感受还很凉爽~
为啥选了抗菌的窗帘?
懂哥这次换的窗帘,主打特色就是银离子抗菌。疫情这几年,消毒喷雾是家中常备,但定期消杀清理窗帘?抱歉我们做不到。
实话讲, 喷雾也很难长久灭活病毒细菌 ,窗帘在窗口,细菌和灰尘有很多都粘附在窗帘上了,再加上窗帘布较厚,藏污纳垢真的是健康隐患。

所以懂哥这次有个重要筛选条件就是健康—— 能否防霉抑菌 。现在市面上有抗菌纤维的*裤内**、袜子,但是抗菌的窗帘在天猫真的很难找,排名、销量比较靠前的天猫店里,基本就某猫这家有抗菌系列窗帘。
窗帘的面料是高达99%抗菌率,能抵抗大肠杆菌、金黄色葡萄球菌、肺炎克雷伯氏菌;抗真菌,强氧化防霉变,抵抗650多种有害微生物。在抗菌防霉的同时保持自净,不留健康隐患。我们在试挂窗帘的时候,媳妇执意问师傅要来小样,喷湿做了72小时的对比实验。看到抗菌布料抑菌效果肉眼可见,才放心去下单的。
左银离子抗菌面料 右边普通面料
知识点:其实李时珍的《本草纲目》就记载,银有六大功效,分别是杀菌、消炎、拔风、祛湿、防毒、鉴毒。很多少数民族都有用银制餐具存放食品保鲜防腐的传统。
穿过耳洞的人都知道,戴银耳环耳朵不容易发炎。

银里面微量的银离子,接触到细菌细胞膜进入细胞,通过与蛋白质化学反应,会破坏蛋白质的结构,使细菌死亡或丧失繁殖能力,从而有效降低细菌和病毒的伤害性。在有抗菌功能的布料附近,基本无处可藏,并且,杀菌后它还可以在后续重复发挥抗菌作用。

▲银杀菌的示意图
银对病菌灭杀有选择性, 只会选择灭活单细胞、负电荷的微生物 (99.9%致病菌和病毒是单细胞带负电荷的),而有益菌更多的是带正电荷的微生物,选择性灭活细菌和病毒,所以加入银离子的纤维不会对人体造成危害,考虑到以后和孩子在窗帘里玩个捉迷藏什么的就更放心了。
因为家里窗帘都是占据一整面墙,所以说有银离子窗帘保护的房间,相当于给家人多了一道防护屏障。

▲次卧的窗帘,某牌的天使宝贝系列
关于窗帘面料细节,我们的3个心得
- 布料质感的选择
好的窗帘商家线下服务都很到位,寄样品、或者叫师傅来试挂别嫌麻烦,检查整体做工也一定留个心。
优质的面料记忆定型,拉扯不容易变形,普通窗帘呢?用不久就变形了。好窗帘不光美美的,还能长久地这样美下去。

▲垂坠感很好,褶是很顺滑的弧形
除了抗菌之外, 新窗帘面料比之前旧的更细腻柔软 ,摸起来还挺舒适,而之前的是比较粗粝感觉的。这在网上选窗帘(和其他软装)的时候经常被忽略掉。

说到做工缝线,选品牌货的话,能感受到一些细节的不同。比如说我们的窗帘采用了定制裁缝的“西装工艺”,细节感满满,垂顺好看挂起来更有质感。

▲这窗帘的挂钩和一般窗帘那种廉价铁钩都不一样,是做工很好的ABS树脂挂钩
2、关于窗帘遮光率
每个窗帘厂家的面料织造工艺不同,针对的场景需求也不一样, “遮光率” 是评判窗帘的一个非常重要的标准~
比如卧室里,要保证睡眠质量的话肯定需要遮光率好一些的。像我家除了有宝宝外,媳妇产后睡眠质量一直不太好,夏天5、6点天就亮了,翻来覆去睡不实。
一开始我们考虑的是选有涂银遮光布的窗帘。但媳妇研究完窗帘遮光,告诉懂哥 酒店常见的那种遮光的化学涂层特别容易老化,也有健康隐患, 不太推荐在家里用。

▲不同房间窗帘所需的遮光率不同,我们都是分别定制的参数
媳妇这次还专门问,窗帘的遮光是不是涂银遮光布啊?后来才知道,窗帘遮光已经有替代方案了,而其中最好的方案,就是在面料中 嵌入黑丝遮光层 。
我们卧室两个帘子,就全部用了 高精密黑丝物理遮光面料。 拉上窗帘以后,我们在卧室能瞬间体会 “伸手不见五指” 的效果。家有投影仪的宝宝们,客厅装这种帘子也特别合适,并且除了遮光,还能隔热。

Tip:在背光处打开手机手电筒模式,压在窗帘照一下,透出来的光越少,遮光效果越好。
3、窗帘的环保

之前对新窗帘是否环保,多少还是有顾虑的,特别怕挥发物超标。网店小二直接给我们看了甲醛检测报告。窗帘进场也没闻到任何异味, 挂完当天我们就直接住了。用米家甲醛仪后续测了两周,已经完全放心。

最近一段时间,我们和宝宝都能安心入睡。经过精挑细选换完窗帘,家居焕然一新,家人用着也踏踏实实。这次换窗帘花了不少心思,也很感慨: 打造自己的小家,需要下功夫,但也真的值得。

▲书房只装纱帘就够了,很美!以后会改造成儿童房
后面也了解了一下个牌子,28年的杭州老牌子,属中高档,全国1000多家店,成品试挂、量尺安装这些都有师傅上门,我们的师傅客客气气的,戴鞋套、帮清洁,整个服务下来也满意。售后维修2年内免收人工费,还提供除尘除螨服务,懂哥感觉性价比还挺高的。
总之作为天猫头部排行的定制窗帘品牌,给我们整体感觉是不踩雷、用得踏实,挺推荐这个牌子的。
大家碰上选窗帘的小纠结,欢迎留言问懂哥哦~家居装修路上的选购难题,让我们一起解决!